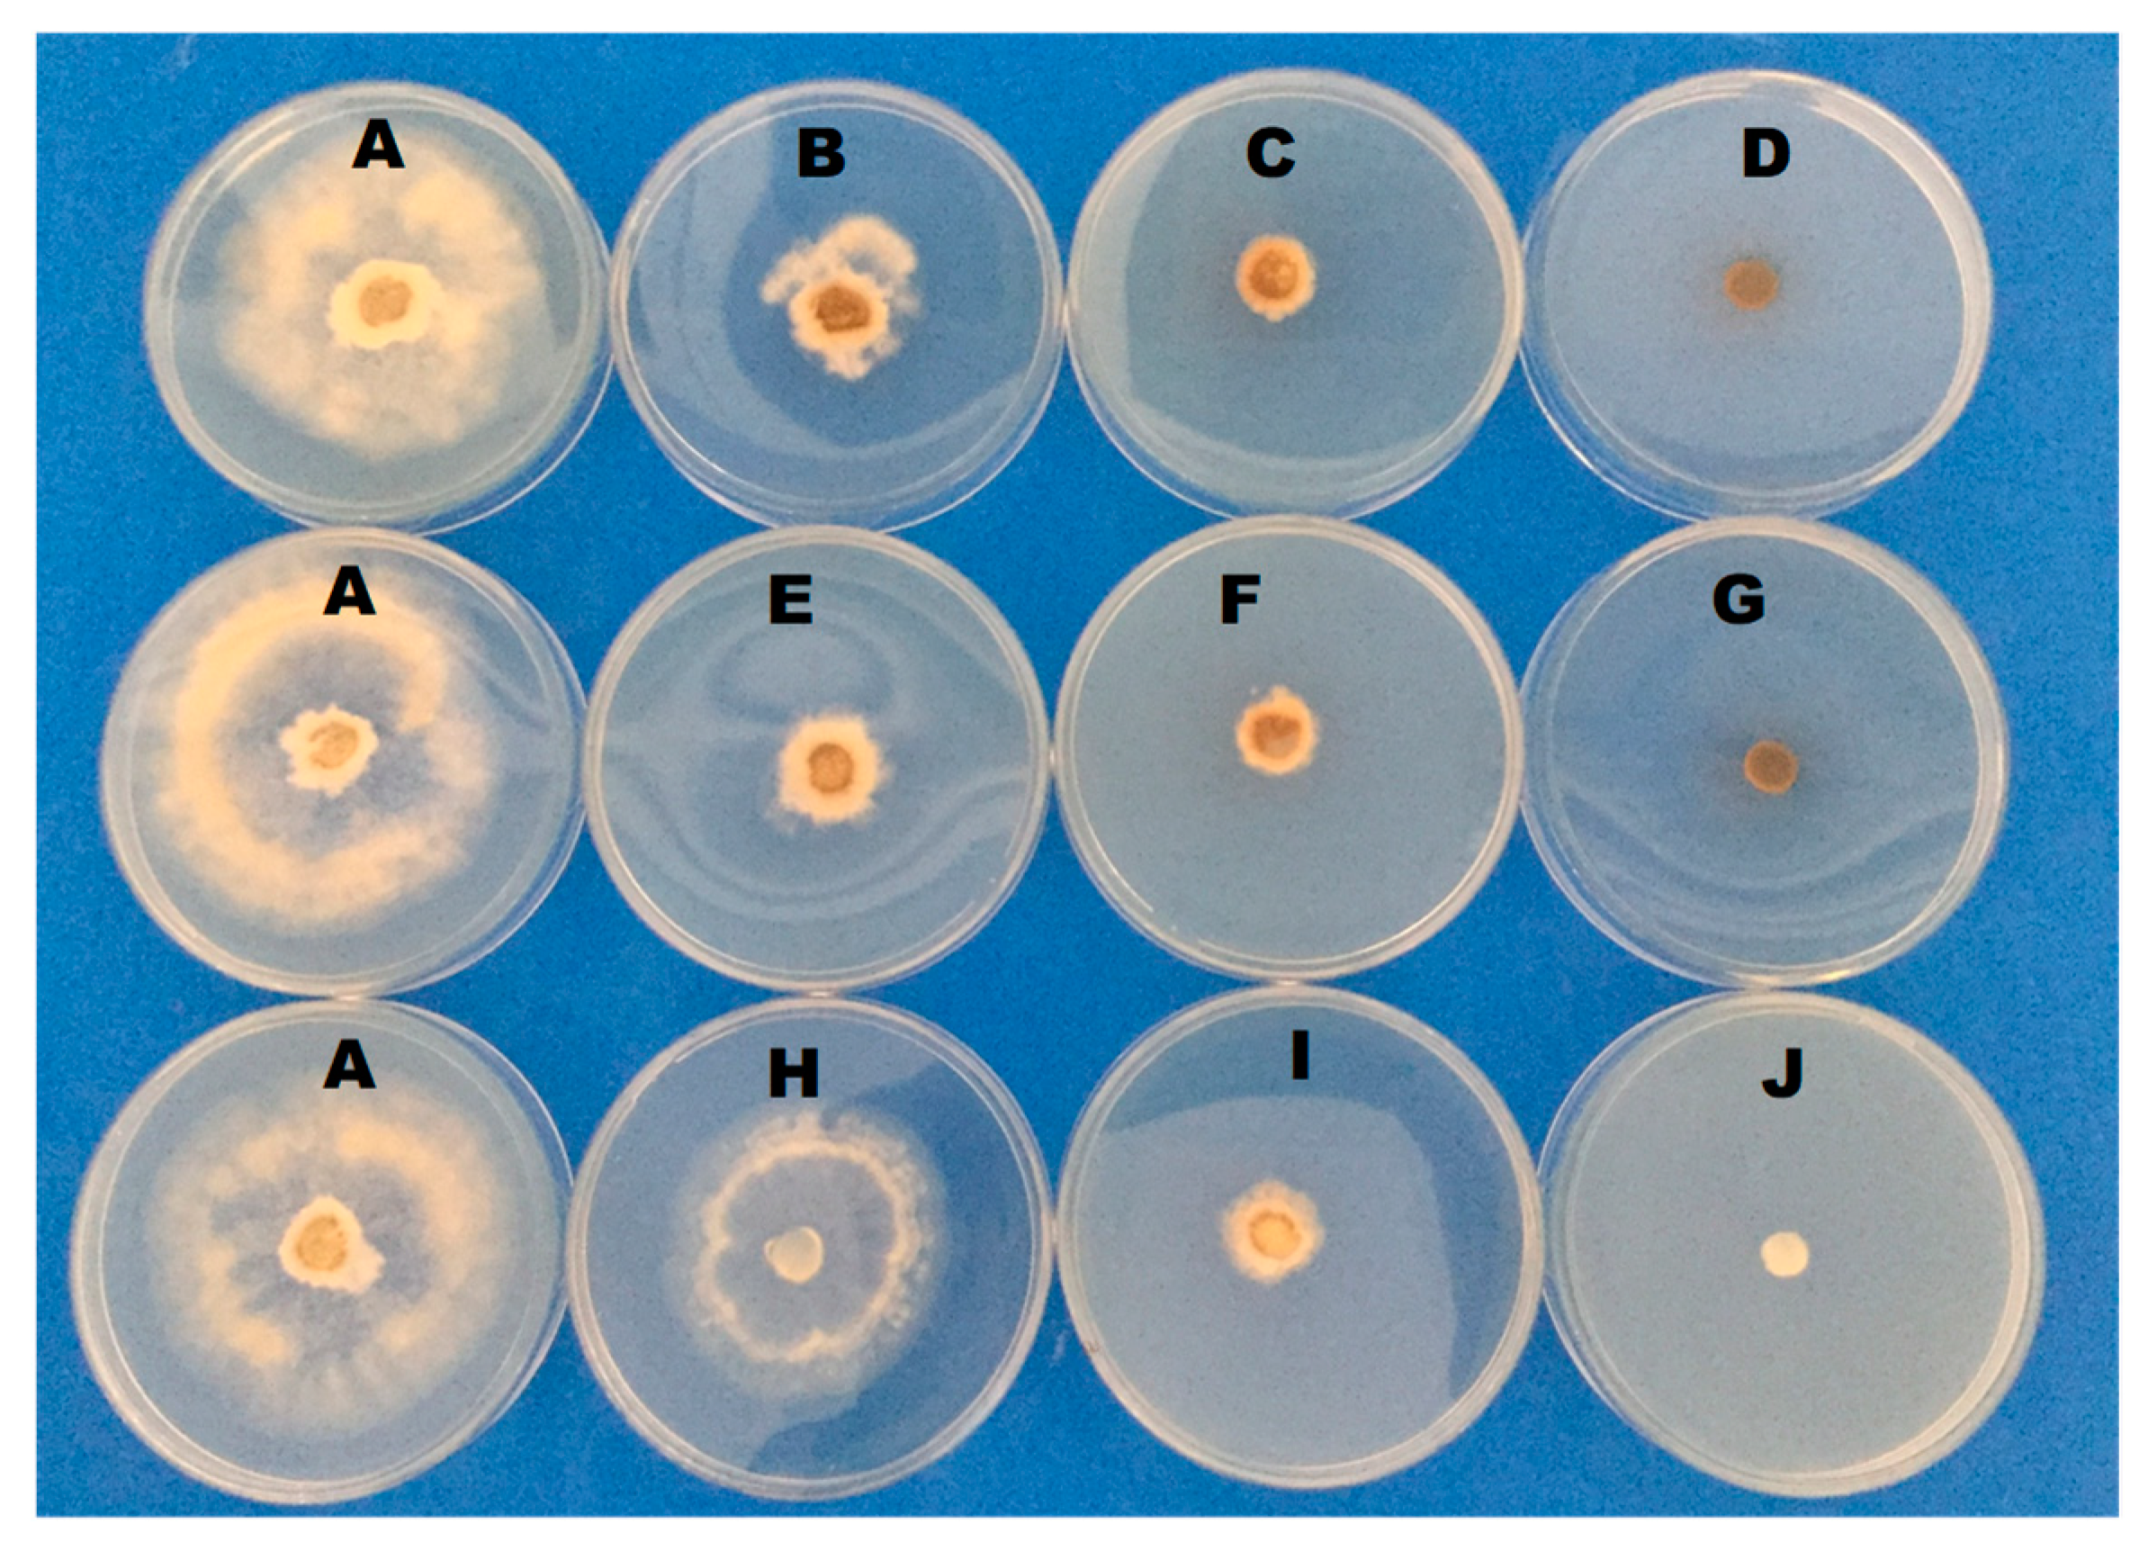

Ultra-Structural Alterations in Botrytis cinerea—The Causal Agent of Gray Mold—Treated with Salt Solutions
Abstract
1. Introduction
2. Materials and Methods
2.1. Chemicals, Fungal Isolate, and Plant Materials
2.2. Effect of Salts on Gray Mold Disease
2.3. Effect of Salts on B. cinerea Radial Growth
2.4. Effect of Salts on B. cinerea Conidial Germination and Germ Tube Elongation
2.5. Scanning Electron Microscopy (SEM)
2.6. Transmission Electron Microscopy (TEM)
2.7. Effect of Salt Solutions on Reactive Species of Oxygen (ROS) Generation
2.8. Effect of Salt Solutions on Conidium Mitochondrial Membrane Potential (MMP)
2.9. Effect of Salt Solutions on Adenosine Triphosphate (ATP) Content
2.10. Statistical Analysis
3. Results and Discussion
3.1. Effect of Salts on Gray Mold Disease
3.2. Effect of Salts on B. cinerea Radial Growth
3.3. Effect of Salts on B. cinerea Conidial Germination and Germ Tube Elongation
3.4. Scanning Electron Microscopy (SEM)
3.5. Transmission Electron Microscopy (TEM)
3.6. Effect of Salt Solutions on Reactive Species of Oxygen (ROS) Generation
3.7. Effect of Salt Solutions on Conidium Mitochondrial Membrane Potential (MMP)
3.8. Effect of Salt Solutions on ATP Content
4. Conclusions
Author Contributions
Funding
Acknowledgments
Conflicts of Interest
References
- FAOSTAT. Available online: http://www.fao.org/faostat/en/#data/QC (accessed on 21 August 2019).
- Dean, R.; Van Kan, J.A.; Pretorius, Z.A.; Hammond-Kosack, K.E.; Di Pietro, A.; Spanu, P.D.; Rudd, J.J.; Dickman, M.; Kahmann, R.; Ellis, J.; et al. The top 10 fungal pathogens in molecular plant pathology. Mol. Plant Pathol. 2012, 13, 414–430. [Google Scholar] [CrossRef] [PubMed]
- Youssef, K.; Roberto, S.R. Applications of salt solutions before and after harvest affect the quality and incidence of postharvest gray mold of ‘Italia’ table grapes. Postharv. Biol. Technol. 2014, 87, 95–102. [Google Scholar] [CrossRef]
- Youssef, K.; Roberto, S.R. Salt strategies to control Botrytis mold of ‘Benitaka’ table grapes and to maintain fruit quality during storage. Postharv. Biol. Technol. 2014, 95, 95–102. [Google Scholar] [CrossRef]
- He, C.; Zhang, Z.; Li, B.; Xu, Y.; Tian, S. Effect of natamycin on Botrytis cinerea and Penicillium expansum-Postharvest pathogens of grape berries and jujube fruit. Postharv. Biol. Technol. 2019, 151, 134–141. [Google Scholar] [CrossRef]
- Jacometti, M.A.; Wratten, S.D.; Walter, M. Review: Alternatives to synthetic fungicides for Botrytis cinerea management in vineyards. Aus. J. Grape Wine Res. 2010, 16, 154–172. [Google Scholar] [CrossRef]
- Nigro, F.; Schena, L.; Ligorio, A.; Pentimone, I.; Ippolito, A.; Salerno, M.G. Control of table grape storage rots by pre-harvest applications of salts. Postharv. Biol. Technol. 2006, 42, 142–149. [Google Scholar] [CrossRef]
- Qin, G.; Zong, Y.; Chen, Q.; Hua, D.; Tian, S. Inhibitory effect of boron against Botrytis cinerea on table grapes and its possible mechanisms of action. Int. J. Food Microbiol. 2010, 138, 145–150. [Google Scholar] [CrossRef]
- Alaoui, F.T.; Askarne, L.; Boubaker, H.; Boudyach, E.I.; Ben Aoumar, A.A. Control of Gray Mold Disease of Tomato by Postharvest Application of Organic Acids and Salts. Plant Pathol. J. 2017, 16, 62–72. [Google Scholar]
- Palou, L. Postharvest Treatments with GRAS Salts to Control Fresh Fruit Decay. Horticulturae 2018, 4, 46. [Google Scholar] [CrossRef]
- Chan, D.C. Mitochondria: Dynamic organelles in disease, aging, and development. Cell 2006, 125, 1241–1252. [Google Scholar] [CrossRef]
- Osiewacz, H.D. Aging in fungi: Role of mitochondria in Podospora anserina. Mech. Ageing Dev. 2002, 123, 755–764. [Google Scholar] [CrossRef]
- Kowaltowski, A.J.; de Souza-Pinto, N.C.; Castilho, R.F.; Vercesi, A.E. Mitochondria and reactive oxygen species. Free Radical Bio. Med. 2009, 47, 333–343. [Google Scholar] [CrossRef] [PubMed]
- Simionato, A.S.; Navarro, M.O.P.; de Jesus, M.L.A.; Barazetti, A.R.; da Silva, C.S.; Simões, G.C.; Balbi-Peña, M.I.; de Mello, J.C.P.; Panagio, L.A.; de Almeida, R.S.C.; et al. The Effect of Phenazine-1-Carboxylic Acid on Mycelial Growth of Botrytis cinerea Produced by Pseudomonas aeruginosa LV Strain. Front Microbiol. 2017, 8, 1102. [Google Scholar] [CrossRef] [PubMed]
- Bocate, K.P.; Reis, G.F.; de Souza, P.C.; Oliveira Junior, A.G.; Durán, N.; Nakazato, G.; Furlaneto, M.C.; de Almeida, R.S.; Panagio, L.A. Antifungal activity of silver nanoparticles and simvastatin against toxigenic species of Aspergillus. Int. J. Food Microbiol. 2019, 291, 79–86. [Google Scholar] [CrossRef] [PubMed]
- Fallanaj, F.; Ippolito, A.; Ligorio, A.; Garganese, F.; Zavanella, C.; Sanzani, S.M. Electrolyzed sodium bicarbonate inhibits Penicillium digitatum and induces defence responses against green mould in citrus fruit. Postharv. Biol. Technol. 2016, 115, 18–29. [Google Scholar] [CrossRef]
- Li, B.; Lai, T.; Qin, G.; Tian, S. Ambient pH stress inhibits spore germination of Penicillium expansum by impairing protein synthesis and folding: A proteomic-based study. J. Proteome Res. 2010, 9, 298–307. [Google Scholar] [CrossRef] [PubMed]
- Guo, Y.; Liu, L.; Zhao, J.; Bi, Y. Use of silicon oxide and sodium silicate for con-trolling Trichothecium roseum postharvest rot in Chinese cantaloupe (Cucumis melo L.). Int. J. Food Sci. Technol. 2007, 42, 1012–1018. [Google Scholar] [CrossRef]
- Bi, Y.; Tian, S.P.; Guo, Y.R.; Ge, Y.H.; Qin, G.Z. Sodium silicate reduces posthar-vest decay on Hami melons: Induced resistance and fungistatic effects. Plant Dis. 2006, 90, 279–283. [Google Scholar] [CrossRef]
- Hervieux, V.; Yaganza, E.S.; Arul, J.; Tweddell, R.J. Effect of organic and inorganicsalts on the development of Helminthosporium solani, the causal agent of potato silver scurf. Plant Dis. 2002, 86, 1014–1018. [Google Scholar] [CrossRef]
- Palou, L.; Usall, J.; Mu˜noz, J.A.; Smilanick, J.L.; Vinas, I. Hot water, sodium carbonate, and sodium bicarbonate for the control of postharvest green and blue molds of Clementine mandarins. Postharv. Biol. Technol. 2002, 24, 93–96. [Google Scholar] [CrossRef]
- Smilanick, J.L.; Mansour, M.F.; Margosan, D.A.; Mlikota Gabler, F.; Goodwine, W.R. Influence of pH and NaHCO3 on effectiveness of imazalil to inhibit germination of Penicillium digitatum and to control postharvest green mold on citrus fruit. Plant Dis. 2005, 89, 640–648. [Google Scholar] [CrossRef] [PubMed]
- Ippolito, A.; Schena, L.; Pentimone, I.; Nigro, F. Control of postharvest rots of sweet cherries by pre- and postharvest applications of Aureobasidium pullulans in combination with calcium chloride or sodium bicarbonate. Postharv. Biol. Technol. 2005, 363, 245–252. [Google Scholar] [CrossRef]
- Gregori, R.; Borsetti, F.; Neri, F.; Mari, M.; Bertolini, P. Effects of potassium sorbate on postharvest brown rot of stone fruit. J. Food Prot. 2008, 71, 1626–1631. [Google Scholar] [CrossRef] [PubMed]
- Li, Y.C.; Bi, Y.; Ge, Y.H.; Sun, X.J.; Wang, Y. Antifungal activity of sodium silicate on Fusarium sulphureum and its effect on dry rot of potato tubers. J. Food Sci. 2009, 74, 213–218. [Google Scholar] [CrossRef] [PubMed]
- Youssef, K.; Mustafa, Z.M.M.; Al-Essawy, A. Efficacy of alkaline and acidic electrolysed water generated by some salt solutions against gray mold of table grape: Pre and postharvest applications. J. Phytopathol. Pest Manag. 2018, 5, 1–21. [Google Scholar]
- Youssef, K.; Ligorio, A.; Sanzani, S.M.; Nigro, F.; Ippolito, A. Evaluation of direct activity and induction of resistance of some common food additives against green mold of citrus fruit. J. Plant Pathol. 2010, 92, 67. [Google Scholar]
- Youssef, K.; Ligorio, A.; Nigro, F.; Ippolito, A. Activity of salts incorporated in wax in controlling postharvest diseases of citrus fruit. Postharv. Biol. Technol. 2012, 65, 39–43. [Google Scholar] [CrossRef]
- Youssef, K.; Ligorio, A.; Sanzani, S.M.; Nigro, F.; Ippolito, A. Control of storage diseases of citrus by pre- and postharvest application of salts. Postharv. Biol. Technol. 2012, 72, 57–63. [Google Scholar] [CrossRef]
- Hussien, A.; Ahmed, Y.; Al-Essawy, A.; Youssef, K. Evaluation of different salt-amended electrolysed water to control postharvest moulds of citrus. Tropical Plant Pathol. 2018, 43, 10–20. [Google Scholar] [CrossRef]
- Liu, J.; Zong, Y.; Qin, G.; Li, B.; Tian, S. Plasma membrane damage contributes to antifungal activity of silicon against Penicillium digitatum. Curr. Microbiol. 2010, 61, 274–279. [Google Scholar] [CrossRef]
- Huang, Y.J.; Chang, P.F.L.; Huang, J.W.; Lin, J.J.; Chung, W.H. Effect of Nanoscale Silicate Platelets on Azoxystrobin-resistant Isolates of Botrytis cinerea from Strawberry In Vitro and In Vivo. J. Plant Pathol. Microbiol. 2016, 7, 194–199. [Google Scholar] [CrossRef]
- Kim, S.W.; Kim, K.S.; Lamsal, K.; Kim, Y.J.; Kim, S.B.; Jung, M.; Sim, S.J.; Kim, H.S.; Chang, S.J.; Kim, J.K.; et al. An in vitro study of the antifungal effect of silver nanoparticles on oak wilt pathogen Raffaelea sp. J. Microbiol. Biotechnol. 2009, 19, 760–764. [Google Scholar] [PubMed]
- Lamsal, K.; Kim, S.W.; Jung, J.H.; Kim, Y.S.; Kim, K.S.; Lee, Y.S. Application of silver nanoparticles for the control of colletotrichum species in vitro and pepper anthracnose disease in field. Mycobiol. 2011, 39, 194–199. [Google Scholar] [CrossRef] [PubMed]
- He, L.; Liu, Y.; Mustapha, A.; Lin, M. Antifungal activity of zinc oxide nanoparticles against Botrytis cinerea and Penicillium expansum. Microbiol. Res. 2011, 166, 207–215. [Google Scholar] [CrossRef] [PubMed]
- Miguel, T.A.; Bordini, J.G.; Saito, G.H.; Andrade, C.G.; Ono, M.A.; Hirooka, E.Y.; Vizoni, E.; Ono, E.Y. Effect of fungicide on Fusarium verticillioides mycelial morphology and fumonisin B(1) production. Braz. J. Microbiol. 2015, 46, 293–299. [Google Scholar] [CrossRef] [PubMed]
- Hashim, A.F.; Youssef, K.; Abd-Elsalam, K.A. Ecofriendly nanomaterials for controlling gray mold of table grapes and maintaining postharvest quality. Eur. J. Plant Pathol. 2019, 154, 377–388. [Google Scholar] [CrossRef]
- Shi, X.Q.; Li, B.Q.; Qin, G.Z.; Tian, S.P. Antifungal activity of borate against Colletotrichum gloeosporioides and its possible mechanism. Plant Dis. 2011, 95, 63–69. [Google Scholar] [CrossRef] [PubMed]
- Pezet, R.; Pont, V. Ultrastructural observations of pterostilbene fungitoxicity in dormant conidia of Botrytis cinerea Pers. J. Phytopathol. 1990, 129, 29–30. [Google Scholar] [CrossRef]
- Avis, T.J.; Rioux, D.; Simard, M.; Michaud, M.; Tweddell, R.J. Ultrastructural alterations in Fusarium sambucinum and Heterobasidion annosum treated with aluminum chloride and sodium metabisulfite. Phytopathol. 2009, 99, 167–175. [Google Scholar] [CrossRef] [PubMed]
- Rasooli, I.; Rezaei, M.B.; Allameh, A. Growth inhibition and morphological alterations of Aspergillus niger by essential oils from Thymus eriocalyx and Thymus x-porlock. Food Control 2006, 17, 359–364. [Google Scholar] [CrossRef]
- Liu, X.; Wang, L.P.; Li, Y.C.; Li, H.Y.; Yu, T.; Zheng, X.D. Antifungal activity of thyme oil against Geotrichum citri-aurantii in vitro and in vivo. J. Appl. Microbiol. 2009, 107, 1450–1456. [Google Scholar] [CrossRef] [PubMed]
- Jeong, J.; Kim, C.; Yoon, J. The effect of electrode material on the generation of oxidants and microbial inactivation in the electrochemical disinfection processes. Water Res. 2009, 43, 895–901. [Google Scholar] [CrossRef] [PubMed]
- Singh, L.P.; Gill, S.S.; Tuteja, N. Unraveling the role of fungal symbionts in plant abiotic stress tolerance. Plant Sign. Behav. 2011, 6, 175–191. [Google Scholar] [CrossRef] [PubMed]
- Qin, G.; Liu, J.; Cao, B.; Li, B.; Tian, S. Hydrogen peroxide acts on sensitive mitochondrial proteins to induce death of a fungal pathogen revealed by proteomic analysis. PLoS ONE 2011, 6, e21945. [Google Scholar] [CrossRef] [PubMed]
- Liu, J.; Sui, Y.; Wisniewski, M.; Droby, S.; Tian, S.; Norelli, J.; Hershkovitz, V. Effect of heat treatment on inhibition of Monilinia fructicola and induction of disease resistance in peach fruit. Postharv. Biol. Technol. 2012, 65, 61–68. [Google Scholar] [CrossRef]
- Shi, X.; Li, B.; Qin, G.; Tian, S. Mechanism of antifungal action of borate against Colletotrichum gloeosporioides related to mitochondrial degradation in spores. Postharv. Biol. Technol. 2012, 67, 138–143. [Google Scholar] [CrossRef]
- Li, Y.; Shao, X.; Xu, J.; Wei, Y.; Xu, F.; Wang, H. Tea tree oil exhibits antifungal activity against Botrytis cinerea by affecting mitochondria. Food Chem. 2017, 234, 62–67. [Google Scholar] [CrossRef] [PubMed]
- Ji, D.; Chen, T.; Ma, D.; Liu, J.; Xu, Y.; Tian, S. Inhibitory effects of methyl thujate on mycelial growth of Botrytis cinerea and possible mechanisms. Postharv. Biol. Technol. 2018, 142, 46–54. [Google Scholar] [CrossRef]
- Acton, B.M.; Jurisicova, A.; Jurisica, I.; Casper, R.F. Alterations in mitochondrial membrane potential during pre-implantation stages of mouse and human embryo development. Mol. Hum. Repr. 2004, 10, 23–32. [Google Scholar] [CrossRef] [PubMed]
- Helmerhorst, E.J.; Troxler, R.F.; Oppenheim, F.G. The human salivary peptide histatin 5 exerts its antifungal activity through the formation of reactive oxygen species. Proc. Natl. Acad. Sci. USA 2001, 98, 14637–14642. [Google Scholar] [CrossRef] [PubMed]

| Salts | Mycelial Growth (mm) | |||
|---|---|---|---|---|
| 24 h | 48 h | 72 h | 96 h | |
| Control | 19.2a | 38.8a | 60.8a | 79.2a |
| PB 0.1% | 13.2b | 18.0c | 29.2c | 34.0c |
| PB 0.2% | 10.8d | 13.6e | 14.8f | 16.8f |
| PB 0.3% | 0.0e | 0.0f | 0.0g | 0.0g |
| SSi 0.1% | 12.8bc | 15.6d | 23.2d | 27.2d |
| SSi 0.2% | 10.4d | 12.8e | 14.4f | 15.6f |
| SSi 0.3% | 0.0e | 0.0f | 0.0g | 0.0g |
| CCh 0.1% | 18a | 32.8b | 41.6b | 48.0b |
| CCh 0.2% | 11.6cd | 18.8c | 20.4e | 21.2e |
| CCh 0.3% | 0.0e | 0.0f | 0.0g | 0.0g |
© 2019 by the authors. Licensee MDPI, Basel, Switzerland. This article is an open access article distributed under the terms and conditions of the Creative Commons Attribution (CC BY) license (http://creativecommons.org/licenses/by/4.0/).
Share and Cite
Youssef, K.; Roberto, S.R.; de Oliveira, A.G. Ultra-Structural Alterations in Botrytis cinerea—The Causal Agent of Gray Mold—Treated with Salt Solutions. Biomolecules 2019, 9, 582. https://doi.org/10.3390/biom9100582
Youssef K, Roberto SR, de Oliveira AG. Ultra-Structural Alterations in Botrytis cinerea—The Causal Agent of Gray Mold—Treated with Salt Solutions. Biomolecules. 2019; 9(10):582. https://doi.org/10.3390/biom9100582
Chicago/Turabian StyleYoussef, Khamis, Sergio Ruffo Roberto, and Admilton G. de Oliveira. 2019. "Ultra-Structural Alterations in Botrytis cinerea—The Causal Agent of Gray Mold—Treated with Salt Solutions" Biomolecules 9, no. 10: 582. https://doi.org/10.3390/biom9100582
APA StyleYoussef, K., Roberto, S. R., & de Oliveira, A. G. (2019). Ultra-Structural Alterations in Botrytis cinerea—The Causal Agent of Gray Mold—Treated with Salt Solutions. Biomolecules, 9(10), 582. https://doi.org/10.3390/biom9100582







